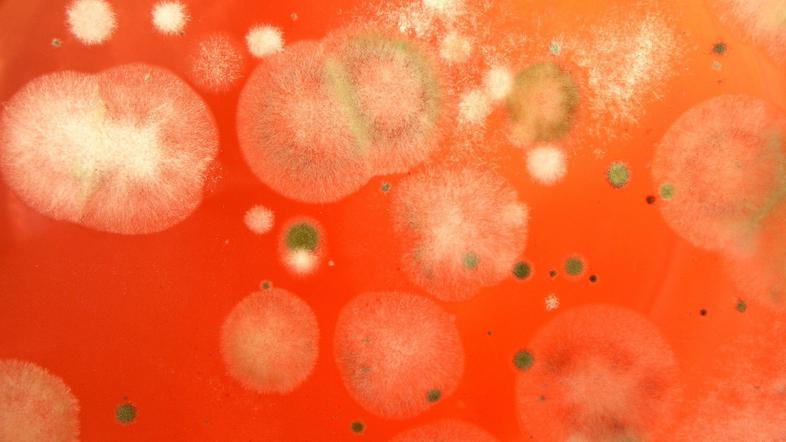

Plesen, ki naseljuje naše domove, je lahko izjemno nevarna, zato se je je treba znebiti, opozarjajo strokovnjaki. Plesni poleg tega, da ustvarjajo grde temne madeže, ustvarjajo tudi neprijeten vonj in so škodljive za ljudi, saj lahko povzročajo alergije in pustijo poledice na dihalih.
Plesen je večcelična puhasta gliva z micelijem, ki se razvije pretežno v vlažnih prostorih, ki so slabo zračeni.
Črna stena v spalnici
Poglejmo primer: V spalnici, kjer spite z zakoncem, ste ugotovili, da se vam je za omaro nabrala plesen. Ste pomislili, da je zaradi tega lahko ogroženo tudi vaše zdravje?
Posledice so lahko hude
Na Nacionalnem inštututu za javno zdravje (NIJZ) pojasnjujejo, da tako imenovana skrita plesen po dolgem času lahko povzroči alergijska dihalna obolenja; bolezni zgornjih dihalnih poti, alergijsko vnetje očesne veznice, krvavitev iz nosu, alergijsko vnetje nosne sluznice in sinusov, kašelj, simptomi podobni gripi ali prehladu, alergijski atopijski dermatitis, astmo ali poslabšanje astme in prebavne težave.

Plesen, ki naseljuje naše domove, je torej lahko izjemno nevarna, zato se je je treba znebiti. Vpliva na zdravje, prek alergijskih mehanizmov, strupenih učinkov mikotoksinov, so dražljivci sluzničnih membran in povzročajo okužbe dihal.
Plesen izloča toksične snovi
Dolgotrajna izpostavljenost plesni lahko povzroči zastrupitev organizma, saj plesen sprošča toksine tudi miktotoksine, ki rastejo na veliko hranilih. Poleg uživanja mikotoksinov smo ljudje in živali tem toksičnim snovem izpostavljeni tudi z vdihavanjem in prek stika s kožo: "Mikotoksini so toksični za večino notranjih organov, kot so pljuča, reproduktivni organi, jetra, ledvica in osrednji živčni sistem. Mikotoksini so naravni kontaminanti hrane in jih ne moremo popolnoma odstraniti pred uživanjem hrane. Trenutne znanstvene ugotovitve kažejo, da ni dovolj verodostojnih dokazov, da je zdravje prebivalcev ogroženo zaradi vdihavanja mikotoksinov v notranjem okolju," pojasnjujejo naši strokovnjaki, ki opozarjajo, da so mikotoksini nevarni pri uživanju plesnive hrane in so strupeni za večino notranjih organskih sistemov, nekateri celo rakotvorni v dovolj velikih koncentracijah.
Najbolj ranljivi zaradi plesni so bolniki z astmo ali s cistično fibrozo, pri katerih se lahko razvije alergijska bronhopulmonalna aspergiloza, ki je težja oblika imunsko pogojene bolezn. Stroka opozarja na posebno ranljivost otrok.
Svetovna zdravstvena organizacija je ocenila, da pri otrocih plesni najpogosteje povzročajo kašelj, alergijsko vnetje nosne sluznice, alergijsko vnetje očesne veznice in astmo.
Otroci, ki živijo v vlažnem bivalnem prostoru, kar pomeni relativno vlažnost nad 75 odstotkov, imajo večje tveganje za razvoj astme , in sicer 1,5- do 2,2-krat večje v primerjavi z otroki, ki živijo v ustreznem bivalnem okolju.
Plesni so večcelične glive in v notranjem okolju rastejo pri različnih temperaturah in ravneh relativne vlažnosti. Najnižja relativna vlažnost, pri kateri začnejo rasti kolonije plesni, je 75 odstotkov.
Kako ukrepamo?
Plesni se lahko znebimo s čiščenjem (profesionalnim) in vzdrževanjem okolja s primerno temperaturo in relativno vlažnostjo. V primeru, da zbolimo za eno izmed oblik preobčutljivosti, poiščemo pomoč pri zdravniku, ki bo s prisotnostjo protiteles v krvi na alergene plesni ali kožnih testov glede na alergene plesni ter telesnim pregledom in funkcijskimi preiskavami odločil za nadaljnje zdravljenje, dodajajo na NIJZ.
Glede hrane, ki jo uživamo, predvsem rastlinske, moramo biti pozorni, da le ta ni kontaminirana s plesnijo, ki proizvaja mikotoksine, kajti dolgotrajno uživanje mikotoksinov je toksično za večino organskih sistemov.
To so preventivni ukrepi pred plesnijo
- Spremljanje vzdrževalnih del in izvajanje rednih pregledov prisotnosti plesni, ocena prekomerne vlažnosti in opredelitev morebitnih puščanj na stavbi in njenih sistemih,
- vsakršno puščanje vode ali probleme s prekomerno vlago je treba takoj javiti vzdrževalcem,
- v primeru puščanja ali razlitja vode je treba v intervalu 24 do 48 ur očistiti in posušiti vlažne gradbene materiale ter pohištvo,
- vlago v notranjih prostorih je priporočljivo vzdrževati med 40 % in 60 %: prezračevati je treba stranišča, garderobe; naprave za prezračevanje in klimatizacijo stavb je treba redno vzdrževati.
Na NIJZ še opozarjajo, da je treba ne le uničiti plesni, ampak tudi počistiti vse ostanke. V večini primerov plesni ni mogoče povsem odstraniti, v zraku namreč še vedno ostane nekaj spor. Te spore pa se ne bodo razmnoževale, če poskrbimo za primerno relativno vlažnost in temperaturo v prostoru.